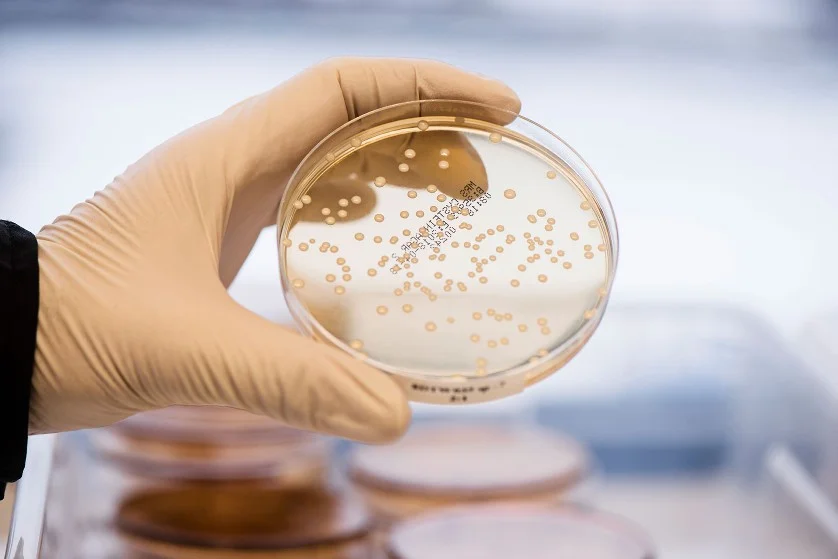

Internal genital organs
- Vagina
- Uterus
- Fallopian Tubes
- Ovaries

Internal Reproductive Organs

The internal genital tract, including (the female reproductive system), consists of:
- The vagina.
- The uterus.
- The two fallopian tubes.
- The ovaries.
The Vagina
- Fibromuscular canal lined with stratified squamous epithelium that leads from the uterus to the vulva.
- Longer in the posterior wall (9 cm) than in the anterior wall (7 cm).
- The vaginal walls are normally in apposition, except at the vault where they are separated by the cervix.

The vault of the vagina is divided into four fornices:
- Posterior
- Anterior
- Two lateral
The vagina has no gland. It is kept moist by secretions from:
- The uterine secretions.
- Cervical glands secretions.
- Transudation from its epithelial lining.

The epithelium is thick and rich in glycogen, which increases in the postovulatory phase of the cycle.
- Before puberty and after the menopause, the vagina is devoid of glycogen due to the lack of oestrogen.
- Doderlein’s bacillus is a normal vaginal flora and breaks down glycogen to form lactic acid producing a pH of around 4.5.
- This has a protective role for the vagina in decreasing the growth of pathogenic bacteria.
Relations of the Vagina
- Posteriorly:
- ✓ The upper part is related to the reflection of the pouch of Douglas.
- ✓ The middle part is separated from the rectum by pelvic fascia.
- ✓ The lower third is related to the perineal body.
- Anteriorly:
- ✓ The upper part is related to the base of the bladder.
- ✓ The middle & lower parts are related to the urethra.


- Laterally:
- ✓ Cardinal ligaments.
- ✓ Levator ani muscles.
- ✓ Ischiorectal fossae.
Supports of the Vagina
- ✓ The cardinal ligaments.
- ✓ The uterosacral ligaments.

The Uterus
- The uterus in non-pregnant state is situated entirely within the pelvis.
- It has muscular walls.
- Its dimensions are:
- 7.5 cm long.
- 5 cm wide.
- 3 cm thick.
- An adult uterus weighs approximately 70 g.

- In the upper part of the uterus is termed the body or ‘corpus’.
- The area of insertion of each Fallopian tube is termed the ‘cornu’.
- The body above the cornu is called the ‘fundus’.
- The uterus tapers to a small constricted area, the isthmus.
- Below this is the cervix (the lower part), which projects obliquely into the vagina.

Uterine Position: Anteversion and Anteflexion
- The longitudinal axis of the uterus is approximately at right angles to the vagina and normally tilts forward.
- This is called ‘anteversion’.
- The uterus is also usually flexed forward on itself at the isthmus – anteflexion.
- In around 20% of women, the uterus is tilted backwards, known as retroversion and retroflexion.
- This has no pathological significance in most women.
Although retroversion that is fixed and immobile may be associated with endometriosis.

The cavity of the uterus is the shape of an inverted Triangle.
- The Fallopian tubes open at lateral angles.
- The constriction at the isthmus where the corpus joins the cervix is the anatomical os:
- Seen microscopically.
- Histological internal os is where the mucous membrane of the isthmus becomes that of the cervix.

Uterine Layers
The uterus consists of three layers:
- ✓ Outer serous layer (peritoneum).
- ✓ Middle muscular layer (myometrium).
- ✓ Inner mucous layer (endometrium).

- The peritoneum covers the body of the uterus and posteriorly it covers the supravaginal part of the cervix.
- The peritoneum laterally spreads out to form the leaves of the broad ligament.
- The muscular myometrium forms the main bulk of the uterus.

- Externally, the muscle fibres are longitudinal.
- Intermediate interlacing longitudinal, oblique and transverse fibres.
- Internally, they are longitudinal and circular.
- The inner endometrial layer has glands that dip into the myometrium.
- The endometrial layer is covered by a single layer of epithelium.
- The endometrium undergoes cyclical changes during menstruation.

The Cervix
- The cervix is 2.5 cm in length.
- Lateral to the cervix: lies the ureter within the parametrium.
- Posteriorly: the cervix is covered by the peritoneum of the pouch of Douglas.
- It has glands that secrete clear alkaline mucus (physiological vaginal discharge).
- The epithelium of the endocervix is columnar and changes to squamous epithelium in the external os.
- The junction between them is the ‘squamocolumnar junctions’.

Age-Related Changes of the Uterus
- Disappearance of maternal oestrogens after birth causes the uterus to decrease in length.
- During childhood, the uterus grows slowly in length, in parallel with height and age.
- After the onset of puberty, the diameters of the uterus start to increase and reach its adult size by the late teenage years.
- After the menopause, the uterus atrophies.

The Fallopian Tubes
- The Fallopian tube extends outwards from the uterine cornu to end near the ovary.
- At the abdominal ostium, the tube opens into the peritoneal cavity. This is essential (Why?) to allow the sperm and egg to meet.
- The Fallopian tubes transfer the ovum from the ovary to the uterus and promote oxygenation and nutrition for sperm, ovum, and then for zygote.
- The Fallopian tube runs in the upper margin of the broad ligament, known as the mesosalpinx, so peritoneum encloses the tube completely, except for a narrow strip along this inferior aspect.

Parts of the Fallopian Tube
- Each tube is about 10 cm long and described in four parts:
- The interstitial portion (lies within the wall of the uterus).
- The isthmus (a narrow portion adjoining the uterus).
- The ampulla (the widest and longest portion).
- The infundibulum or fimbrial portion (where ampulla terminates).

Fallopian Tube
General Characteristics
The opening of the tube into the peritoneal cavity is surrounded by finger-like processes, known as fimbria. Its inner surface is covered by ciliated epithelium. The muscle fibber arranged in: inner… circular outer… longitudinal layer.
There are Changes under the influence of the menstrual cycle but… there is no cell shedding during menstruation.

The Ovaries
General Description and Size Variation
- The size and appearance depends on:
- ✔️ age.
- ✔️ and stage of the menstrual cycle.
- ○ In a child, the ovaries are small structures.
- ○ In the young adult:
- ✔️ they are almond-shaped.
- ✔️ measure approximately 3 cm long.
- ✔️ 1.5 cm wide and 1 cm thick.
- ○ After the menopause, no active follicles and the ovary becomes smaller.

Unique Peritoneal Covering
The ovary is the only intra-abdominal structure not to be covered by peritoneum.
Ligaments of the Ovary
- ovarian ligament between the ovary & the cornu of the uterus by the.
- Mesovarium of the broad ligament:
- Suspend the ovaries (but not cover them)
- Contains nerves & blood vessels.
- suspensory ligament:
- Which attach each ovary to the pelvic side wall.


Internal Structure of the Ovary
- The ovary has a central vascular medulla.
- It has an outer thicker cortex.
- The surface of the ovaries is covered by cuboidal cells, (the germinal epithelium).
- Beneath this is ‘tunica albuginea’, which increases in density with age.
- At birth, numerous primordial follicles are found.
- With puberty, some form each month into the graafian follicles under gonadotrophic control to ovulate then form corpus lutea or corpus albicans.
